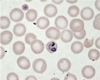
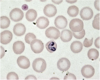

In simple terms, as a reminder..
What is a parasite?
An organism that is metabolically + physiologically dependent on another organism (host)
Name the main differences between an Ecto + Endoparasites?
They are divided into the sites that they infect or infest.
Endoparasites =
* Live on the outer body of the host + feed on exterior
* Feed on external structures such as; sucking blood, lymph, feathers, hair, skin + secretions
* Most are arthropods (invertebrates with joint legs, hard exoskeletions) such as; lice, ticks, mites, fleas, bugs, flies + mosquitoes
Ectoparasites =
* Live on the inner body of the host + feed in the interior
* Feed on internal structures such as; gut, tissues + organs
* Most are worms
In simple terms, as a reminder..
What does a parasite do to it’s host in order to survive?
It exploits the host for its development + survival during 1 or more stages in its life cycle
Name a class of single-celled parasite
Protozoa
Name 2 classes of multi-cellular parasites
- Worms
- Arthropods
Think what ‘high’ is in medical nomenclature..
What is the phenomenon called where 2 or more parasites can occur in the same host, at the same time?
Poly or hyper-parasitism
If a host is experiencing Hyper or Poly-parasitism, what is the host’s state known as?
Co-infected
With scientific-latin nomenclature of parasites, what is the 1st name called?
Genus
With scientific-latin nomenclature of parasites, what is the 2nd name called?
Species name
Name 6 things that are required to be correct when writing the scientific nomenclature of parasites
- Genus name 1st
- Captial letter for the Genus name
Ixodes ricinus
- Species name 2nd
- Lower case letter for the Species name
Ixodes ricinus
- Both names Italicized
- Scientific names normally only mentioned once, then abbreviated with the initial of the genus, then species name
What is the genus?
The taxonomic rank or level of biological classification between family and species
What does the ‘site of predilection’ mean, when talking about parasites?
The parasites preffered site of final development (within the hosts body)
Predilection = in favour of/preffered
When trying to name a parasite, what can the organ of preference help with?
Define it’s most common location, thus, giving a clue to what it depends on for survival + the affects it has on the host = gives it’s name!
Name the 5 main taxonomic groups of parasites
- Nematoda (roundworms)
- Cestoda (tapeworms)
- Trematoda (flatworms)
- Arthropoda (Insects + acarines)
- Protozoa
Give the latin name of this parasite.
+
How many other names has this got? Name them.

It’s the dorsal view of Ixodes ricinus !
(Tick)
It has 3 names:
1. Sheep tick
1. Wood tick
1. Deer tick
Give the common name of the ectoparasite that these mouthparts belong to, adapted to sucking blood from their host + transmit infections

Brown dog tick
(Rhipicephalus sanguineus)
What does the prefix Rhipi + cephalus mean in Rhipicephalus sanguineus?
- Rhipi = derived from the greek word ‘Rhiphis’
= fan-like (mouthpart shape, presumably) - Cephalus = lating for head
fan-like (mouthpart shape, presumably)
What does the suffix sanguineus mean in Rhipicephalus sanguineus?
Latin for sanguis
= blood
Or to be specific ‘to have the colour of blood’, from early french..
Give the common name + the latin name of this adult endoparasite in a do.
+
What part of the body is this?

- Common name =
Intestinal roundworm - Latin name = Toxocara canis
- SI
SI = Small Intestines
What are obligatory + facultative obligatory parasites?
- Obligatory parasites
= need a host to complete their life cycle - Facultative parasites
= can complete their life cycle without a host + only under certain conditions can they opportunistically enter the host + produce infection
Name 3 ways in which a parasite can develop drug resistance.
They;
1. Produce an enzyme that destroys the drug
2. Alter the molecular target so that it is no longer sensitive to the drug
3. Prevent access to the target, by actively pumping the drug out of the parasite
What is one major symptom that Lyme disease causes?
Multiple organ faliure
What infamous deadly disease is transmitted from ticks?
Lyme disease
Name endoparasites A + B.

A) (Intestinal roundworm in Dogs + Cats) - Adult Toxocara canis
B) (Most common Intestinal roundworm in Cats) - Adult Toxocara cati